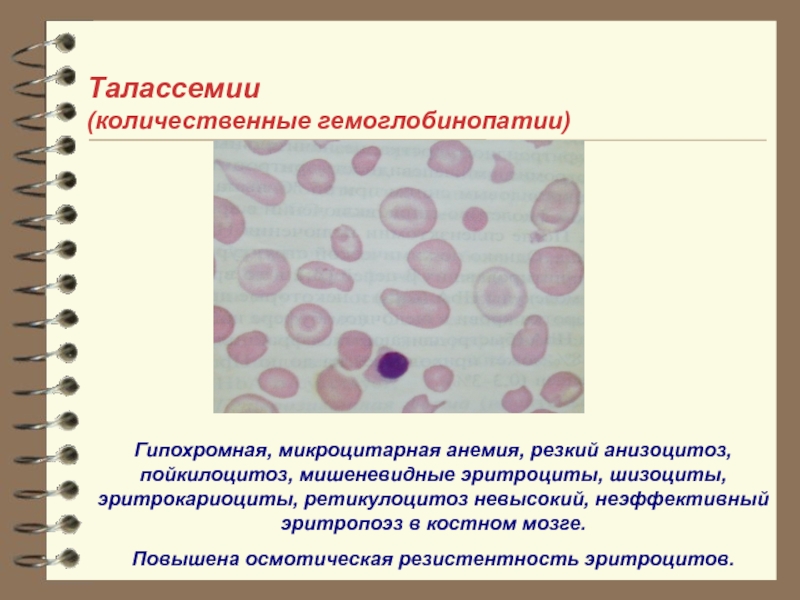

- Главная
- Разное
- Дизайн
- Бизнес и предпринимательство
- Аналитика
- Образование
- Развлечения
- Красота и здоровье
- Финансы
- Государство
- Путешествия
- Спорт
- Недвижимость
- Армия
- Графика
- Культурология
- Еда и кулинария
- Лингвистика
- Английский язык
- Астрономия
- Алгебра
- Биология
- География
- Детские презентации
- Информатика
- История
- Литература
- Маркетинг
- Математика
- Медицина
- Менеджмент
- Музыка
- МХК
- Немецкий язык
- ОБЖ
- Обществознание
- Окружающий мир
- Педагогика
- Русский язык
- Технология
- Физика
- Философия
- Химия
- Шаблоны, картинки для презентаций
- Экология
- Экономика
- Юриспруденция
1 презентация
Содержание
- 3. Гемолитические анемии (Анемии с ретикулоцитозом)
- 4. Общие сведения о процессе гемолиза · Гемолиз - это разрушение
- 5. (заболевание развивается в результате нарушений в строении
- 6. Вторичные (приобретенные) факторы: - переливание крови,
- 9. Механизмы повреждения зависят от конкретного этиологического фактора
- 11. Катаболизм гемоглобина при внутриклеточном гемолизе
- 12. Катаболизм гемоглобина при внутрисосудистом гемолизе
- 13. Сравнительная характеристика внутриклеточного и внутрисосудистого гемолиза
- 14. Классификация гемолитических анемий Наследственные: связанные с нарушением
- 15. Общие диагностические критерии гемолитических анемий 1. Желтуха, которая
- 16. Эритропатии – гемолитические анемии, связанные с нарушением структуры мембраны эритроцитов
- 17. Эритропатии Акантоцитоз- нарушение липидов мембраны Стоматоцитоз
- 18. Микросфероцитарная гемолитическая анемия (болезнь Миньковского-Шоффара) В основе
- 19. Гемоглобинопатии Серповидноклеточная анемия.
- 20. Талассемии (количественные гемоглобинопатии) α-талассемия -
- 21. Талассемии (количественные гемоглобинопатии) Гипохромная,
- 22. Иммунные гемолитические анемии 1. Изо- или аллоиммунные
- 23. Иммунные гемолитические анемии 1. Изо- или аллоиммунные
- 24. Аутоиммунная гемолитическая анемия Идиопатическая (без видимой
- 25. Иммунные гемолитические анемии 4 серологических вида:
- 26. Аутоиммунная гемолитическая анемия АИГА с неполными
- 27. Принцип лечения АИГА
- 28. Осложнения гемолитических анемий - гипоксия органов и тканей (в
- 29. Клинические проявления гемолитического криза включают: ·
- 30. 1. Восстановление объема циркулирующей крови (изотонический раствор
- 31. Лечение Медикаментозная терапия: глюкокартиеоиды(преднизолон сут.доза 60-80 мг),цитостатики
- 32. Профилактика гемолитических анемий Профилактика гемолитических анемий разноплановая. Для
- 33. Прогноз при гемолитических анемиях Прогноз имеет индивидуальный характер и
- 34. http://www.medicalj.ru/diseases/urology/751-hronicheskaja-pochechnaja-nedostatochnost http://lechim-pochki.ru/hronicheskaya-pochechnaya-nedostatochnost-simptomyi-i-lechenie/ http://myfamilydoctor.ru/simptomy-xronicheskoj-pochechnoj-nedostatochnosti/ http://www.urolog-site.ru/urolog/hpn.html
- 35. Обратная связь Общие диагностические критерии гемолитических анемий?
- 36. Ответ: 1. Желтуха, которая не сопровождается зудом
- 37. Синквейн Гемолитическая анемия Врожденная Приобретенная Сокращение жизненного
- 38. Синквейн Гемолиз Внутриклеточная Внутрисосудистая
- 39. 1) Эритроцит 2) 3) Транспортирует килород,
Слайд 3
Гемолитические анемии
(Анемии с ретикулоцитозом)
от греческого haima – кровь, lysis -разрушение
Группа
При повышенном кроверазрушении активация эритропоэза за счет выброса эритропоэтина может возрастать в сотни раз, что обеспечивает рост содержания ретикулоцитов в периферической крови на 2-3 порядка.
В ситуации, когда напряженный эритропоэз не может компенсировать кроверазрушения, возникает гемолитическая анемия.
Слайд 4Общие сведения о процессе гемолиза
· Гемолиз - это разрушение эритроцитов с выходом гемоглобина в среду,
· Длительность жизни эритроцита в среднем 120 дней (100-130 дней).
· В организме постоянно происходить физиологический гемолиз вследствие естественного старения эритроцитов.
· В зависимости от локализации гемолиза выделяют анемии с внутриклеточным гемолизом (гемолиз происходит в клетках фагоцитарной системы) и анемии с внутрисосудистым гемолизом (гемолиз происходить в сосудистом русле при участии комплемента).
Слайд 5(заболевание развивается в результате нарушений в строении мембран эритроцитов) – микросфероцитоз
развитие которых связано с нехваткой какого-либо фермента, необходимого для построения эритроцитов;
заболевание связано с наличием дефектных цепей гемоглобина в эритроците. К этой группе заболеваний относятся талассемия и серповидно-клеточная анемия.
Слайд 6Вторичные (приобретенные) факторы:
- переливание крови, несовместимой по группе и резус-фактору;
-
- попадание в организм токсинов, при укусах некоторых видов змей, пауков и насекомых;
- некоторые бактериальные и паразитарные (малярия) инфекции;
- обширные ожоги;
- механические причины (искусственные клапаны в камерах сердца, стенты в сосудах).
Слайд 9Механизмы повреждения зависят от конкретного этиологического фактора (снижение осмотической стойкости эритроцитов
Слайд 11Катаболизм гемоглобина
при внутриклеточном гемолизе
Гемоглобин
Глобин
Гем
Биливердин
Неконьюгированный
билирубин
Гемоксигеназа
Биливердинредуктаза
Fe
Резерв
Неконьюгированный
билирубин
+ альбумин
Пул
аминокислот
Fe + трансферрин
Моно- и диглюкуронил билирубина
(коньюгированный
Билирубин + Глюкуроновая кислота
Глюкуронидаза
Билирубин
Уробилин, уробилиноген,
Стеркобилиноген, стеркобилин
Бактерии
Экскреция
с калом
Глюкуронат-трансфераза
Экскреция
с мочой
Макрофаг
Кровь
Печень
Кишечник
Слайд 12Катаболизм гемоглобина
при внутрисосудистом гемолизе
Гемоглобин
Эритроциты
Гаптоглобин
+ гемоглобин
Метгемоглобин
Гемин (Fe3+)
Альбумин
Гемопексин
Альфа- и бета- димеры
Моно- и
(коньюгированный билирубин)
Глюкуронат-трансфераза
Билирубин
Глюкуронидаза
Уробилин, уробилиноген,
Стеркобилиноген, стеркобилин
Бактерии
Экскреция
с калом
Кровь
Почки
Кишечник
Печень
Экскреция
с мочой
Слайд 14Классификация гемолитических анемий
Наследственные:
связанные с нарушением мембраны
связанные с нарушением активности ферментов
связанные с
Приобретенные:
связанные с наличием антител
связанные с механическим повреждением ЭР
связанные с химическим повреждением ЭР
связанные с недостатком витаминов
связанные с разрушением внутриклеточными паразитами
По скорости:
Острая: минуты – часы
Хроническая: до нескольких дней (рецидивирующая)
Слайд 15Общие диагностические критерии гемолитических анемий
1. Желтуха, которая не сопровождается зудом кожи. Цвет
2. Нормохромная анемия (исключения - гипохромная анемии при талассемии и эритропоэтической протопорфирии) .
3. Значительный ретикулоцитоз периферической крови.
4. Наличие в периферической крови ядросодержащих эритроидных клеток (нормоцитов).
5. Раздражение эритроидного ростка (увеличение эритрокариоцитов в костном мозге более 25%).
6. Повышение в крови неконъюгированного билирубина.
7. Темный цвет мочи. Обусловленный появлением в ней уробилина (при болезни Маркиафавы-Микели и при пароксизмальной Холодовой гемоглобинурии черный цвет мочи обусловлен гемоглобином).
8. Темный цвет кала за счет увеличенного количества стеркобилина..
9. Повышение в крови свободного гемоглобина (при внутрисосудистом гемолизе).
10. Увеличение селезенки (при внутриклеточном гемолизе).
11. Уменьшение продолжительности жизни эритроцитов (проба с радиоактивным хромом).
12. Увеличение железа в сыворотке крови.
Слайд 17Эритропатии
Акантоцитоз-
нарушение липидов мембраны
Стоматоцитоз - дефицит мембранного протеина 1
Элиптоцитоз - дефект
Слайд 18Микросфероцитарная гемолитическая анемия
(болезнь Миньковского-Шоффара)
В основе – дефицит белков мембраны эритроцитов –
в селезенке.
Лечение: основной метод лечения - спленэктомия. При значительной анемии и отказе больного от оперативного вмешательства - переливание эритроцитарной массы.
характерны специфические признаки: аномалии развития («башенный череп», «готическое небо», синдактилия и др.)
Слайд 19
Гемоглобинопатии
Серповидноклеточная анемия.
Связанное с наследственным нарушением синтеза гемоглобина (появлением гемоглобина S со
Слайд 20
Талассемии
(количественные
гемоглобинопатии)
α-талассемия - снижение синтеза α-цепей
Hb Bart’s (γ4)
Hb H (β4)
β-талассемия: снижение
Hb A2 (α2δ2)
Hb F (α2γ2)
Наследственные гемолитические анемии, обусловленныенарушением синтеза полипептидных цепей глобина вследствие делеции генов, кодирующих синтез Hb.
Слайд 21
Талассемии
(количественные гемоглобинопатии)
Гипохромная, микроцитарная анемия, резкий анизоцитоз, пойкилоцитоз, мишеневидные эритроциты, шизоциты,
Повышена осмотическая резистентность эритроцитов.
Слайд 22Иммунные гемолитические анемии
1. Изо- или аллоиммунные
а/т против а/г эритроцитов
- гемолитическая болезнь
посттрансфузионные
2. Трансиммунные
а/т мамы с аутоиммунными а/т через плаценту к плоду
3. Гетероиммунные (гаптеновые)
фиксация лекарства на эритроците с образованием патологического антигена; гаптеном может быть вирус
4. Аутоиммунные
а/т против эритроцитов периферии; а/т против эритрокариоцитов костного мозга – парциальная красноклеточная аплазия.
Слайд 23Иммунные гемолитические анемии
1. Изо- или аллоиммунные
а/т против а/г эритроцитов
- гемолитическая болезнь
посттрансфузионные
2. Трансиммунные
а/т мамы с аутоиммунными а/т через плаценту к плоду
3. Гетероиммунные (гаптеновые)
фиксация лекарства на эритроците с образованием патологического антигена; гаптеном может быть вирус
4. Аутоиммунные
а/т против эритроцитов периферии; а/т против эритрокариоцитов костного мозга – парциальная красноклеточная аплазия.
Слайд 24Аутоиммунная гемолитическая анемия
Идиопатическая (без видимой причины)
Симптоматическая – вторичная (гемобластозы, миелома, СКВ,
Слайд 25Иммунные гемолитические анемии
4 серологических вида:
1. с неполными тепловыми агглютининами
2. с тепловыми
3. с полными холодовыми агглютининами
4. с двухфазными гемолизинами
Слайд 26Аутоиммунная гемолитическая анемия
АИГА с неполными тепловыми агглютининами
АИГА с тепловыми гемолизинами
АИГА с
Пароксизмальная холодовая гемоглобинурия с двухфазными гемолизинами
Пароксизмальная ночная гемоглобинурия (болезнь Маркиафава-Микели)
Слайд 28Осложнения гемолитических анемий
- гипоксия органов и тканей (в первую очередь страдают головной мозг
- Гемолитический криз - это синдром, который характеризуется резким обострением клинических и лабораторных признаков гемолиза эритроцитов.
Слайд 29Клинические проявления гемолитического криза включают:
· сильные боли в животе, преимущественно в
· дурноту, рвоту, исчезновение аппетита;
· в некоторых случаях учащение испражнения;
· головнуя боль, головокружение;
· в тяжелых случаях - появление судорог;
· усиление бледности кожи и желтухи;
· тахикардию, повышение температуры тела;
· усиление потемнения силы;
· увеличение печени и селезенки;
· увеличение анемии и ретикулоцитоза,
· лейкоцитоз со сдвигом лейкоцитарной формулы влево;
· увеличение СОЭ.
Слайд 301. Восстановление объема циркулирующей крови (изотонический раствор натрия хлорида или раствор
2. Нейтрализация токсических продуктов и стимуляция диуреза (для форсированного диуреза - фуросемид 80 мг (1% 8 мл) в/в, для дезинтоксикации - реосорбилакт 400-800 мл в/в капельно).
3. Ликвидация ацидоза (4% раствор гидрокарбоната натрия 200-400 мл в/в капельно).
4. Плазмаферез, гемодиализ.
5. Переливание отмытых эритроцитов и размороженных эритроцитов (если уровень гемоглобина <50 г/л)
Лечение гемолитического криза
Слайд 31Лечение
Медикаментозная терапия: глюкокартиеоиды(преднизолон сут.доза 60-80 мг),цитостатики
Иммунодепрессанты(метотрексат,циклофосфамид)
Дезинтоксикационная терапия
Витаминотерапия
Антибактериальная терапия
При повышении желаза -
Гемотрансфузия - при гемалитич.кризах
Хирургическое лечение - спленоэктомия
Слайд 32Профилактика гемолитических анемий
Профилактика гемолитических анемий разноплановая. Для наследственных гемолитических анемий она включает медико-генетическое
Слайд 33Прогноз при гемолитических анемиях
Прогноз имеет индивидуальный характер и зависит от вида гемолитической анемии, тяжести
Слайд 34http://www.medicalj.ru/diseases/urology/751-hronicheskaja-pochechnaja-nedostatochnost
http://lechim-pochki.ru/hronicheskaya-pochechnaya-nedostatochnost-simptomyi-i-lechenie/
http://myfamilydoctor.ru/simptomy-xronicheskoj-pochechnoj-nedostatochnosti/
http://www.urolog-site.ru/urolog/hpn.html
Слайд 36Ответ:
1. Желтуха, которая не сопровождается зудом кожи. Цвет кожи лимонно-желтый с
2. Нормохромная анемия (исключения - гипохромная анемии при талассемии и эритропоэтической протопорфирии) .
3. Значительный ретикулоцитоз периферической крови.
4. Наличие в периферической крови ядросодержащих эритроидных клеток (нормоцитов).
5. Раздражение эритроидного ростка (увеличение эритрокариоцитов в костном мозге более 25%).
6. Повышение в крови неконъюгированного билирубина.
7. Темный цвет мочи. Обусловленный появлением в ней уробилина (при болезни Маркиафавы-Микели и при пароксизмальной Холодовой гемоглобинурии черный цвет мочи обусловлен гемоглобином).
8. Темный цвет кала за счет увеличенного количества стеркобилина..
9. Повышение в крови свободного гемоглобина (при внутрисосудистом гемолизе).
10. Увеличение селезенки (при внутриклеточном гемолизе).
11. Уменьшение продолжительности жизни эритроцитов (проба с радиоактивным хромом).
12. Увеличение железа в сыворотке крови.
Слайд 37Синквейн
Гемолитическая анемия
Врожденная
Приобретенная
Сокращение жизненного цикла эритроцитов
Проявляется желтухой
Повышается непрям билирумин
Возникает гипергемоглобинемия
Слайд 391) Эритроцит
2)
3) Транспортирует килород, насыщает клетки, симулирует эритропоэтин
4) Красные кровяные
5) Кровоток
Синквейн